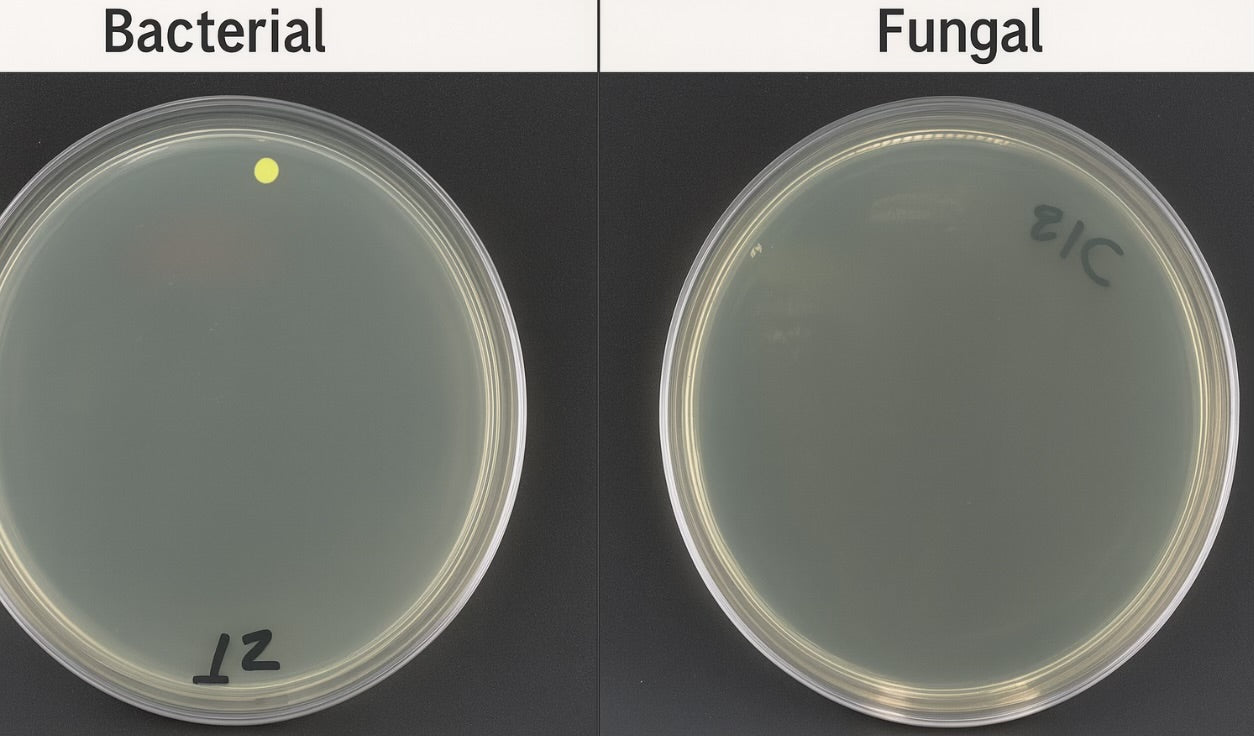
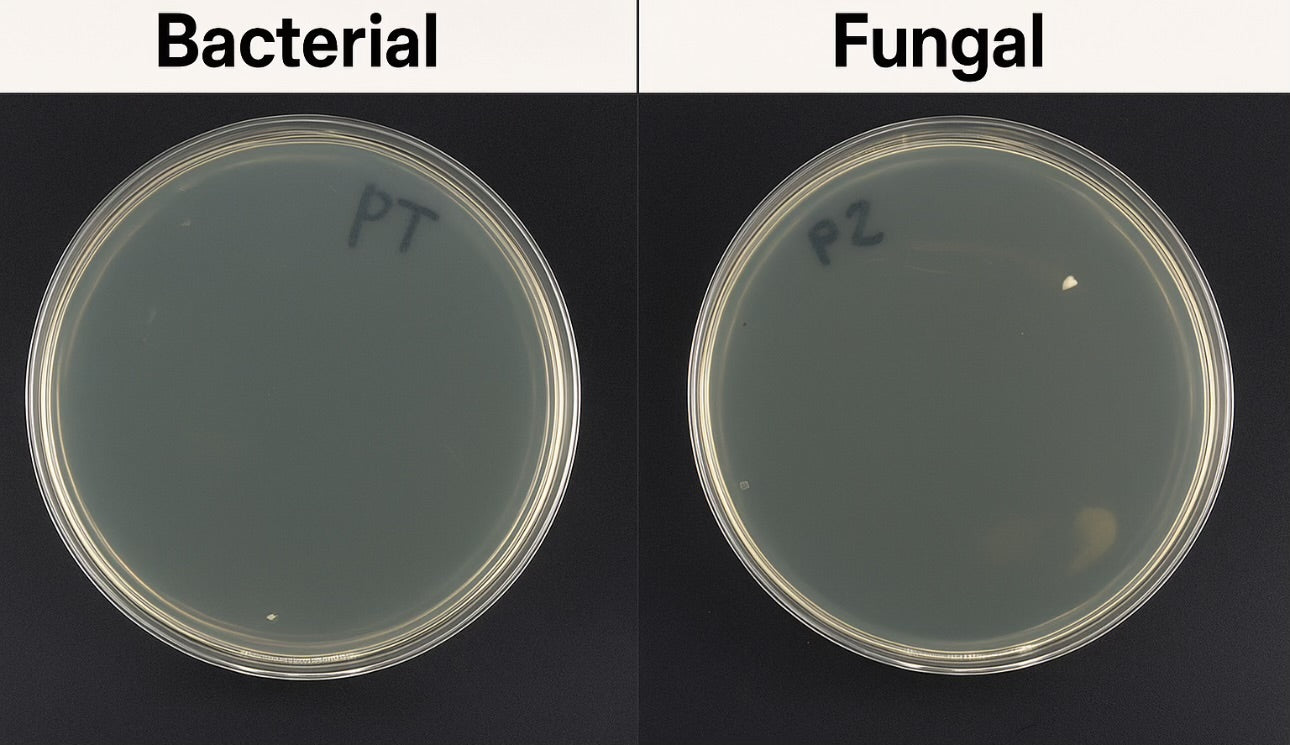

My Store
WynnShield Protective Antimicrobial Wrap
Share














What is WynnShield™?
The WynnShield™ is a protective wrap powered by Microban®, a world-leading antimicrobial brand. Specially designed to serve as a temporary surface for mobile devices, the WynnShield™ surface with Microban® Antimicrobial Technology stays up to 99.9% cleaner than an untreated surface, ensuring continuous microbial reduction throughout the lifespan of the wrap. Keeping your device cleaner for longer.
How It Works

Without WynnShield

Without WynnShield

With WynnShield
Multicolumn
-
Column
Pair text with an image to focus on your chosen product, collection, or blog post. Add details on availability, style, or even provide a review.
-
Column
Pair text with an image to focus on your chosen product, collection, or blog post. Add details on availability, style, or even provide a review.
-
Column
Pair text with an image to focus on your chosen product, collection, or blog post. Add details on availability, style, or even provide a review.
Featured products
-
WynnShield for Mophie Juice Pack (Epic Rover) Apple IPhone SE
Regular price From $44.95 USDRegular priceUnit price / per -
WynnShield Protective Antimicrobial Wrap
Regular price From $34.95 USDRegular priceUnit price / per



